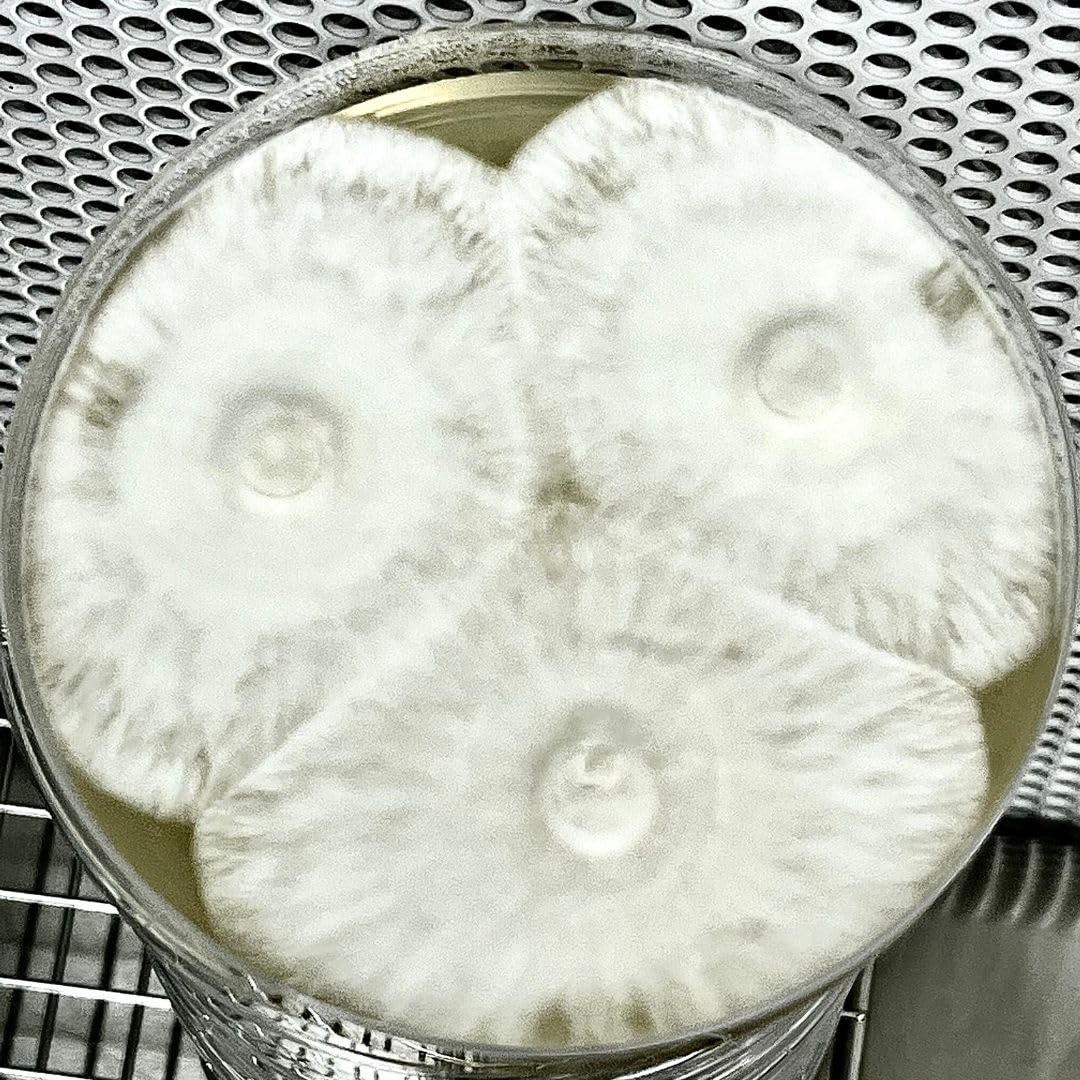
Thumbnail 5

🌟 Elevate Your Experiments with Premium Agar Plates!
BASEMENT CULTURE offers a premium 5-pack of sterile potato dextrose agar plates, designed for optimal growth in mushroom cultivation and biological experiments. Each dish is pre-sterilized, ensuring a contamination-free environment, and features a balanced nutrient profile to support a wide variety of microorganisms. With excellent customer support and a versatile application range, these agar plates are perfect for both educational and professional use.
S**I
Worked well
Bought these for my daughters since project, they worked pretty well.
A**Z
No contamination so far! More than happy with the purchase.
I was very skeptical about getting pre-made agar since I am barely a begginer, and saw many more recommended choices and saw a lot of bad batches coming with contamination.I decided to give these a try since I saw one cool review that seemed honest enough. Bought two to try and oh boi am I happy? Yes! After inoculating with prints, on day 5 I could see some grow already and no contamination.Package is amazing, some slight condensation but that's normal, no contamination and each plate is inside a vacuum sealed bag.Very happy and will purchase again in the future. Highly recommended!
C**1
Works Great !
Product works well received in a promptly manner, unfortunately, two out of the five plates had mold or bacterial growth and were thrown out the other 3 had no issues
P**N
Green mold
I had the same green mold in every dish. I think it came contaminated.
R**P
cost effective sterility checks
these work well for R/O system sterility checks. after buying 1 ml sterile pipettes and collection cups, i performed satisfactory sterility checks on my R/O system without paying too much. 2-3 day incubation at room temp seemed to work well.
J**I
Are these a bit too nutrient rich? I can't tell.
I have some plates that sort of grow and then I have some that go nuts. I found that potato dextrose is best for mycology but the malt works as well. The issue I am having is that sometimes there are so many nutrients or something that I don't get those lovely strands of mycelia. I get a puffy cotton candy. it still grows into wonderful mushrooms but I can't figure out why some plates will cause the culture to grow outwards while others puff up. I can take a sample from the same exact plate and put it on some brands and they become puffy clouds - then transfer to another branch and it spreads out in a nice consistent mycelium growth.Either way, I like these. I would probably end up screwing up my own agar mix if I tried it myself.
S**S
Don't refrigerate- you will end up with liquid pooling in the shipped bags!
Huge disappointment with these. Seller never posted not to refrigerate their product. We refrigerate to slow down the possibility of contamination, a standard practice. We pulled these out after the 30-day return window had passed to use them so seller will not replace. Don't expect leniency with this particular seller.Don't refrigerate, and make sure if yours comes with any issues you rifle back a replacement request through Amazon to save you the hastle. As it turned out, we didn't risk using these- a complete waste of time and money. You may not have the same experience. These are basic agar potato dishes, nothing extraordinary, and are shipped in a solid box plus sealed. My issue is seller never warned not to refrigerate.
G**
Mixed feelings
Well this is my first time using potato agar, and 3 out of the 5 my spawn got contaminated with trichoderma, all work is done in my clean room under a flow hood so I'm not sure if the agar was contaminated or not but what didn't get contaminated is thriving
Trustpilot
1 month ago
2 months ago